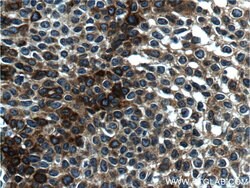
Cytokeratin 14 Mouse anti-Human, Mouse, Clone: 2G1E2, Proteintech 20 &mu;L | Buy Online | Proteintech | Fisher Scientific

missing translation for 'onlineSavingsMsg'
Learn More
Learn More
Description
Cytokeratins (CK) are intermediate filaments of epithelial cells, both in keratinizing tissue (ie. skin) and non-keratinizing cells (ie. mesothelial cells). At least 20 different CKs can be identified. Biochemically, most members of the CK family fall into one of two classes, type I (acidic polypeptides) and type II (basic polypeptides). Belonging to the type I subfamily of low molecular weight keratins and existing in combination with keratin 5, keratin 14 distinguishes stratified epithelial cells from simple epithelial cells and is useful in identification of squamous cell carcinomas. It is considered a prognostic marker in breast carcinomas. At least one member of the acidic family and one member of the basic family is expressed in all epithelial cells.
Specifications
Specifications
| Antigen | Cytokeratin 14 |
| Applications | Immunocytochemistry, Western Blot, Immunofluorescence, Immunohistochemistry (Paraffin) |
| Classification | Monoclonal |
| Clone | 2G1E2 |
| Concentration | 0.75 mg/mL |
| Conjugate | Unconjugated |
| Formulation | PBS with 50% glycerol and 0.02% sodium azide; pH 7.3 |
| Gene | KRT14 |
| Gene Accession No. | P02533, Q61781 |
| Gene Alias | CK 14, CK14, Cytokeratin 14, EBS3, EBS4, K14, keratin 14, KRT14, NFJ |
| Show More |
Product Title
By clicking Submit, you acknowledge that you may be contacted by Fisher Scientific in regards to the feedback you have provided in this form. We will not share your information for any other purposes. All contact information provided shall also be maintained in accordance with our Privacy Policy.
Spot an opportunity for improvement?